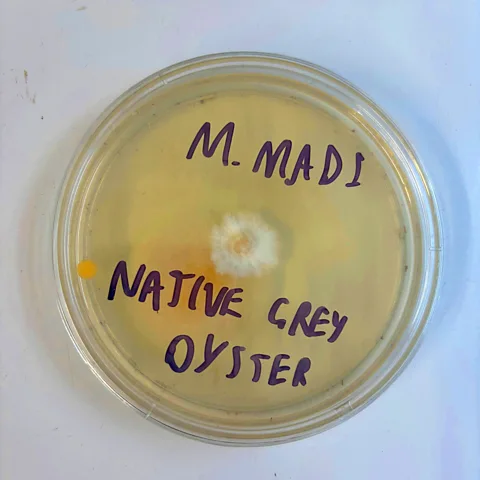
Mohamed Madi My cloning experiment was successful, with a white fuzz of mycelium spreading out from the piece of mushroom flesh I cut from a grey oyster mushroom (Credit: Mohamed Madi)

An unstoppable mushroom is tearing through North American forests. Fungi enthusiasts are doing damage control
 Getty Images
Getty ImagesA rogue mushroom native to Asia is ripping through North American forests, after escaping from cultivation. As it runs riot, mushroom enthusiasts are rescuing the native fungi in its path.
The razor blade of the newly unpacked surgical scalpel glints in the late Autumn light. I spray alcohol sanitiser on the work surface, rub my hands religiously, and try not to sneeze.
I am about to clone a mushroom – a pristine grey oyster, its smooth cap the colour of a cloud just about to burst.
This is not how I imagined my first time cloning something would be. I'm not in a sterile laboratory – I'm in a tent in a muddy field in Sussex in the UK with dozens of other campers, at the annual All Things Fungi Festival. Many are wearing furry mushroom-themed hats or jumpers. A few metres away a medicine woman chimes a gong as she leads a fungi-themed "sound bath" session.
But not all mushrooms are to be celebrated here. There is one so vigorous and invasive that it has been banned from the festival altogether: the golden oyster mushroom. This fungus has torn its way through North American forests and spread its spores across Europe from Italy to Hungary.
My efforts to clone a native grey oyster are a small part of the fight to protect more vulnerable fungi from the rampant advance of invaders like the golden oyster mushroom.
 Aishwarya Veerabahu
Aishwarya VeerabahuA golden killer
The golden oyster mushroom (Pleurotus citrinopileatus) is a close cousin of the grey oyster I dissected above. Instead of grey, it has a neon yellow cap, and it is prolific. The fungus itself mainly grows on dead or dying hardwood trees, breaking down the tough wood fibres. Golden oysters are "gilled mushrooms", and a single gilled mushroom can release up to billions of spores. Oyster mushrooms also happen to be one of the few carnivorous mushrooms – preying mercilessly on nematode worms.
It is invisible for most of the year, living as mycelium, fungal strands within the wood. But beginning in spring, it sends out its fruiting body – what we would recognise as the mushroom itself. Huge yellow clusters cascade out of logs and trees, each mushroom itself producing millions of microscopic airborne spores.
Native to Asia, the fungus was brought over to the US to be cultivated for food sometime around the early 2000s. Because it fruits so heavily, it proved to be popular with both professional and home growers. It has a high yield, meaning more profit for growers.
The mushroom is now found across the world. It's spreading in Switzerland, and has been found in Italy, Hungary, Serbia and Germany. There are reports of the golden oyster growing in the south of the UK too. The Royal Horticultural society has issued advice warning people against growing non-native species, especially the golden oyster, saying it was "highly invasive" and capable of causing "severe damage" to local fungal communities.
Aishwarya Veerabuhu, a mycologist at the University of Wisconsin-Madison who's studied the golden oyster, says it wasn't long before it escaped into the wild.
"Community scientists were like, whoa! This thing is bright yellow, so it's very easy to notice," she says. "It's now been found in 25 US states and one Canadian province."
Other types of oyster mushroom have long existed in North America, breaking down dead and dying trees, playing a crucial role in ensuring that waste matter doesn't just accumulate in forests. But golden oysters are different. Aishwarya and her team of researchers drilled into trees to look at the exact makeup of the fungi within. What they found shocked them.
"We found that trees colonised by golden oyster have, on average, about half the fungal biodiversity as trees without the golden oyster. And so that was a huge indicator that they're likely out competing the native fungi that were there," says Veerabahu.
Put simply, the ecosystem in North America was ripe for invasion by the prolific golden fungus. Local fungi, which had coevolved with local trees and plants over millions of years, could not keep up.
Aishwarya says we still don't understand all the implications of that loss of diversity.
"Dead wood is a crucial habitat for small animals and tree seedlings in the forest. Also, this mushroom grows and 'chews' through woods so rapidly – so what does this mean for the rate of decay of wood, and for the carbon emissions that come from that?"
The worry is that by changing the makeup of the fungi within the forest, there are cascading and unpredictable effects down the line, with implications for the whole ecosystem. (Read more about the race to preserve the necrobiome.)
 Aishwarya Veerabahu
Aishwarya VeerabahuHelping native species hold on
It may be almost impossible to halt the spread of the golden oyster entirely, but it is possible to give other species a boost – which is where the work of cloning native species of fungus comes in.
My mushroom cloning session, back at the All Things Fungi Festival, is run by Andy Knott. A former engineer and longtime forager, Knott set up his own mushroom farm last year in Dorset after he spotted an opportunity.
"A lot of people are growing non-native species of mushroom from China, America and elsewhere – but why is no one preserving our native genetics?" he says.
It's becoming ever harder to do. Mushrooms like the grey oyster face a growing threat from more vigorous fungi, like the golden oyster, which can easily outcompete them. Just as some invasive plants have created an intractable problem, like Japanese knotweed and Himalayan Balsam, Knott worries the same could become true for fungi. It's a problem created by the way we use, grow and transport fungi – but acting rapidly could save vulnerable fungi from decline or extinction.
"We don't know if, if in 50 years or 100 years' time, what we're doing now might have a massive impact on our native mushroom species," says Knott.
The clones of native species made by Knott and others could help these fungi hold on, even as they come under ever-greater pressure.
 Mohamed Madi
Mohamed MadiAn army of fungal invaders
The golden oyster mushroom may be prolific, but it is far from the only offender.
Ann Pringle, professor of botany at the University of Wisconsin-Madison researches deadly death caps (Amanita Phalloides), which are one of several species now spreading in California and Australia.
"Amanita muscaria, that famous red and white spotted mushroom, is invasive in Colombia, for example, where it associates with native Coast Live Oak. Colombia is the southernmost distribution of oaks in the world. So if you broaden the conversation, there is quite a bit more than just the golden oyster."
Other invasive species meanwhile are appearing in Europe. In October 2025, Poland's national forest management body sounded the alarm after a North American species, the slender golden bolete (Aureoboletus projectellus) was found in the Unesco-protected Białowieża Forest.
"[The mushroom's] appearance in the region of a valuable natural site like the Białowieża Forest is a warning sign – nature is changing, and foreign species are more often encroaching on our environment," the agency warned.
Białowieża Forest is home to over 50 species of mammal, including the largest population of wild European bison, once hunted to near extinction. Anything that could upset the balance of the forest is being taken seriously, and Polish authorities have asked for any sightings of the new species to be reported immediately.
Climate change is also believed to be changing the distribution of fungi across the world. One species, the strikingly orange "ping pong bat fungus" (Favolaschia calocera), originally hails from tropical Madagascar. But it's been showing up in the wild in Dorset, southern England, where its effects on native fungi are unknown, something scientists believe is being helped by rising global temperatures.
 Alamy
AlamyGetting fungi on the priority list
Pringle and others think that finally, fungal conversation is being taken as seriously as plant and animal protection.
"When I started teaching mycology, fungi were plants, and you would teach them as if they were plants. Now that we know fungi are their own kingdom, I think it's been a long process of also then thinking that maybe we should be thinking about them distinctly in terms of conservation."
In March this year, the International Union for Conservation of Nature (IUCN) added over 400 species of fungi to its Red List of threatened species. The number of fungi on that list is now over 1,300. In 2014, there were just three.
For Matthew Wainhouse, a fungi specialist at Natural England, it's a long overdue correction.
"There are all of those wonderful functions that fungi do, whether that's decomposition, whether it's mutualisms with plants that enable trees to grow, whether it's food for animals. There are all these things that fungi as a kingdom do, and if we don't conserve those, then the whole system can start to decline."
There are thought to be more than 2 million species of fungus globally, with some estimates putting it as high as 5 million. The vast majority of plants on land are dependent on fungi for their nutrients. "So no fungi, no plants, which is a really wild thing," says Wainhouse.
"They're also habitat creators. Around 1,800 species of birds globally are obligate cavity nesters, meaning that they are completely dependent on a hole in a tree. Well, who's making that hole? That's a fungus."
He's tracking the spread of golden oyster mushroom in the UK with concern. Wainhouse says it's been found in the wild in at least two locations in the south of England, with even more unconfirmed sightings. He advises sightings should be reported to the British Mycological Society.
Moreover, he says the strains that he and his team have found appear to be cultivated varieties that have been especially bred to be both fast growing and fast spreading.
Despite risks like this, fungal conservation is still underfunded and underappreciated, especially when it comes to animals and plants.
"People are more likely to donate money to, you know, doe-eyed animals that remind them of their own babies, so in that sense, fungi are not charismatic. They're not pulling on those same relational heart strings."
A fungal resurgence
But that could be changing, he says, as more people become interested in the fungal kingdom, and take steps to fight back against the fungal invaders.
Andy Knott, who led the fungal cloning session, is part of a network of citizen scientists who find native species around the country, then clone and preserve their genetics.
"We clone them in the lab, and then we're able to resupply those as grain spawn."
His company, Jurassic Coast Mushrooms, supplies native oyster mushroom grow kits to enthusiastic home growers. Unlike non-native species, there is no need to filter the spores to avoid the fungus escaping into the environment. Some go even further and deliberately spread the spores in local forests and gardens, hoping to give a helping hand to native species.
For Knott, preserving native genetics is a critical mission. "They've got seed banks for plants. But it didn't look like anyone was doing it for mushrooms. I want to be that guy."
 Jurassic Coast Mushrooms/ Andy Knott
Jurassic Coast Mushrooms/ Andy KnottBack in the muddy field in Sussex, my mushroom-cloning experiment is one small part of the answer to this. The grey oyster mushroom I have in front of me is itself a clone of a native British variety, found by Andy Knott and his group of volunteers. Today, we'll attempt to clone it again – to make an exact genetic copy of that individual that will help perpetuate its genetics.
Knott had demonstrated the technique for us earlier in the session. First, with clean hands, I pulled apart the mushroom, revealing a marshmallowy, white and, most importantly, sterile interior. Then, hunched next to an air filter which helps take away airborne contaminants, I use my scalpel to cut away a small nugget of white flesh, about the size of a sesame seed.
Next Knott opens an agar plate, and I push the piece I've speared on the end of my scalpel into the jelly. I quickly close the lid and Knott seals up the sides with tape. It's done – if I've managed to keep everything clean and I keep it somewhere warm and dark, I should be able to admire a fresh culture of native Pleurotus ostreatus in just a few weeks. When I got home after the festival, I put it under my boiler, the warmest, darkest place I could think of.
Mohamed Madi
Mohamed MadiA few weeks later, I remember my science experiment.
There was growth. The speck of mushroom in the middle now had lines of thin white mycelium branching out through the agar. There were also unwelcome visitors. A bit of orange mould had taken hold, and some grey too. Clearly I hadn't been careful enough with my sterile process.
Besides, in my London flat, there was little I could do with the culture apart from admire it. I took photos, then put it back under the boiler, unwilling to throw it away just yet. I vowed that the next time I walked in the woods, I'd look a little more closely for that pale grey cap.
--
For essential climate news and hopeful developments to your inbox, sign up to the Future Earth newsletter, while The Essential List delivers a handpicked selection of features and insights twice a week.
For more science, technology, environment and health stories from the BBC, follow us on Facebook and Instagram.
